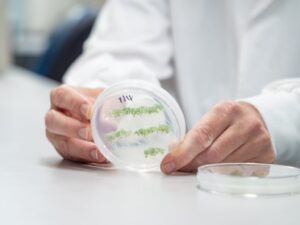
Plant samples at the UQ laboratory (Image: Megan-Pope, UQ)

Moving biopesticides through plants opens new opportunities
By Natalie MacGregor
University of Queensland (UQ) research has revealed that double-stranded RNA-based biopesticides (dsRNA) sprayed on plant leaves can travel right down into root systems. Led by Dr Chris Brosnan at UQ’s Queensland Alliance for Agriculture and Food Innovation (QAAFI), the work also disproves a long-standing misconception that dsRNA directly enters plant cells.
‘Instead, we have shown in multiple species that when it is sprayed on a plant’s leaf, the dsRNA is mobile, travelling between cells and throughout the plant, including to the roots,’ Dr Brosnan said, ‘This study provides clear evidence that dsRNA can act as a systemic, mobile and functional biopesticide in plants.’
Fungal diseases cost the global agriculture sector billions of dollars each year, but chemical fungicides are increasingly restricted due to environmental and human health concerns. Another issue is that many pathogens are developing resistance to some fungicides. RNAi-based biopesticides are an emerging technology representing a sustainable alternative to synthetic chemical-based crop protection strategies. dsRNA-based sprays work by triggering RNA interference (RNAi), which is a natural gene‑silencing process used by plants, fungi, insects and other living organisms.
When disease‑causing fungi infect a plant that has been treated with the dsRNA spray, the fungal cells absorb the RNA and switch off target genes needed for fungal survival or infection. It can kill the pest but does not cause any harm to the plant, other beneficial or non-target organisms.
‘We have shown that dsRNA applied to the leaves travels to stems, roots, shoot tips, flowers and even new tissue, across multiple plant species including Arabidopsis, canola, tomato and native tobacco,’ Dr Brosnan said, ‘We demonstrated that it remains largely unprocessed during this movement and can silence genes in pathogenic fungi that infect distant tissues like roots. We found the dsRNA in roots within just one hour, in flower tissues within 24 hours and in newly formed stems and seed pods two weeks after application. If we are trying to target a pathogen, then this spray technology has a real chance of being effective, because the dsRNA can move systemically, encountering pathogens to kill.’
QAAFI’s Dr Donald Gardiner said the findings were significant, ‘This work changes the dogma around the stability, uptake and movement of dsRNA which is vital as we develop the technology,’ Dr Gardiner said, ‘It validates foliar dsRNA sprays as a sustainable alternative to chemical pesticides, potentially enabling whole-plant protection, including roots, without having to be applied to the soil. Currently, there are no effective sprayable products to target pests and pathogens below the ground. It is a challenge to get anything protective into plant roots, so if we can spray RNA on a leaf and get it to move through the plant’s tissues as an intact molecule to its roots, that is a significant opportunity to target hard-to-reach pests and pathogens. Our work shows that the dsRNA remains detectable in newly developed tissues up to 14 days after application, which is considered long-term stability.’
The scientists say the research could also have applications outside cropping, in wholesale, production and retail nurseries. ‘In nurseries, this technology could eventually be used to ensure that any products developed for sale are free of target pests or pathogens,’ Dr Brosnan said, ‘There is also the possibility that seed treatments could be developed, where the seeds are coated with the protective dsRNA before they’re packaged and sold. That would ensure seedlings are protected during germination and early growth. Many ornamental plants are susceptible to fungal pathogens, so dsRNA could provide an environmentally sustainable solution to that problem for the industry, and, as with crops, this could reduce the reliance on chemical fungicides to control pathogens.’
Dr Brosnan said the team’s next target was to identify root-based organisms highly susceptible to dsRNA. ‘One of the challenges in developing effective RNA-based technologies is the instability of RNA in the soil environment,’ he said, ‘Factors like pH, microbes and other unknown things in the soil can degrade the RNA. Our findings could mitigate this problem, because if the dsRNA is contained in the plant rather than in the soil, it is somewhat protected. But we need to know how this translocated RNA is then transferred to susceptible organisms.
‘One target to reveal this information could be parasitic nematodes, which are a major pest in agriculture, affecting grains, cotton and many important horticultural species. These nematodes are found in soil and water, and feed by taking nutrients from their hosts, leading to stunted growth. They have shown promise in previous research, so there is a possibility we could use the movement of the dsRNA to get to this root-based pathogen. It would also be helpful to find a fungus that was susceptible to this technology. We still need to know how it works in these targets and how to ensure it is highly effective in those organisms. For example, would seed coating or spraying on more mature plants be an effective delivery method?
‘There are still gaps in our understanding of the biological mechanisms behind the unique RNA movement observed in this research,’ Dr Gardiner said, ‘We plan to explore those gaps in future work. We are still a long way from product development, but it is worth further investigation as the potential of this plant protection technology is exciting.’
The research was published in Nucleic Acids Research.
This research was supported by the Genome Innovation Hubat UQ, the Australian Research Council Translational Research Hub for Sustainable crop protectionfrom the Australian Government, as well as support from an Advance Queensland Industry Research Fellowship from the Queensland Government.
The Queensland Alliance for Agriculture and Food Innovation is a research institute at The University of Queensland, established with and supported by the Department of Primary Industries.
Natalie MacGregor
QAAFI Media
M: 0409 135 651
E: n.macgregor@uq.edu.au
W: www.uq.edu.au
